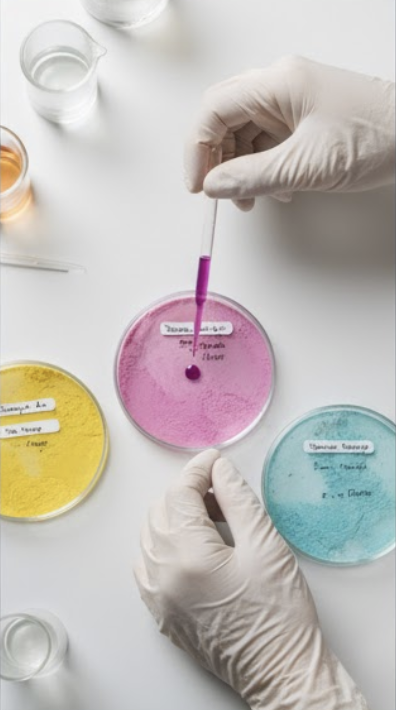

รับผลิตผงน้ำผลไม้หลากหลายรสชาติ ทั้งแบบชงน้ำเย็นและน้ำร้อน คัดสรรวัตถุดิบคุณภาพสูง กลิ่นหอม รสชาติเข้มข้น

พัฒนาและผลิตผงชงดื่มทุกประเภท เช่น ชา กาแฟ โกโก้ ผงชานม หรือเครื่องดื่มเพื่อสุขภาพ (Health & Functional Drinks)
บริการวิจัยและพัฒนาสูตร (R&D) เฉพาะสำหรับแบรนด์ของคุณ โดยทีมนักวิทยาศาสตร์อาหาร (Food Scientist) มืออาชีพ
เราดูแลคุณตั้งแต่แนวคิด… จนถึงสินค้าพร้อมขาย
ปรึกษาและวางแนวคิด: ลูกค้าแจ้งความต้องการและแนวคิดของสินค้า
พัฒนาและทดสอบสูตร: ทีม R&D พัฒนาสูตรและส่งตัวอย่างให้ทดสอบจนกว่าจะพอใจ
ออกแบบและผลิต: ดำเนินการผลิตด้วยมาตรฐานโรงงานสากล (GMP, HACCP)
ส่งมอบสินค้า: ส่งมอบสินค้าคุณภาพสูง พร้อมเอกสารรับรองสำหรับนำไปจัดจำหน่าย

โรงงานมาตรฐานสากล: ได้รับการรับรอง GMP, HACCP มั่นใจได้ในความสะอาด และ ปลอดภัย

ทีม R&D มืออาชีพ: มีนักวิทย์ฯ อาหาร ช่วยพัฒนาสูตรที่แตกต่างและมีเอกลักษณ์

บริการครบวงจร (One-Stop): จบในที่เดียว ทั้งคิดสูตร, ผลิต, บรรจุ, และขอ อย.

รักษาความลับลูกค้า: เราปกป้องสูตรและข้อมูลทางธุรกิจของลูกค้าเป็นสำคัญที่สุด
ติดต่อทีมผู้เชี่ยวชาญของเราเพื่อรับคำปรึกษาและใบเสนอราคาฟรี วันนี้!